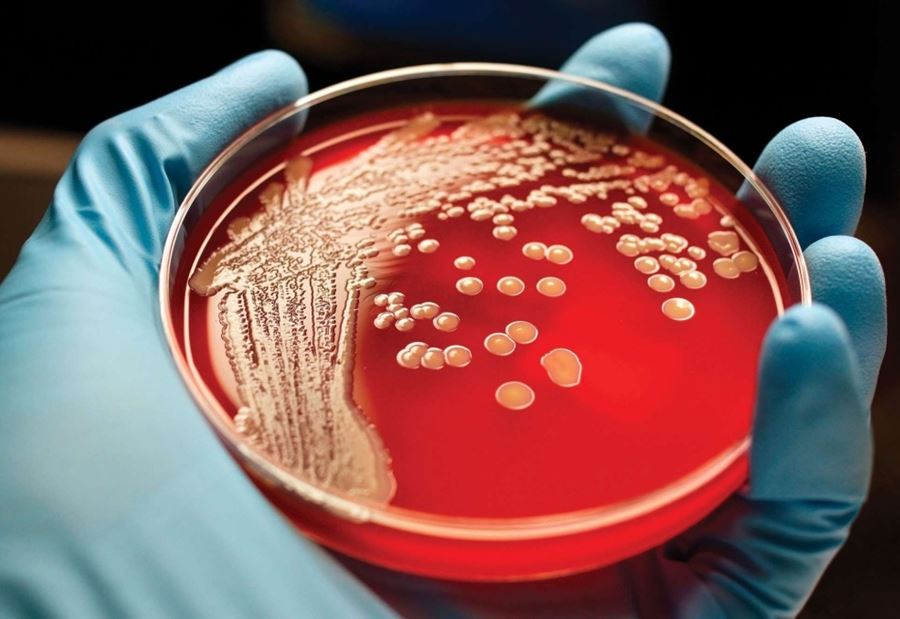

كشفت الطبيبة الروسية يوليا نيناشيفا،أخصائية أمراض الدم، المؤشرات التي يجب الانتباه إليها في نتيجة تحليل الدم، من أجل الوقاية من السرطان.
وأشارت نيناشيفا إلى أن "تحليل الدم السريري، يكشف ليس فقط انخفاض مستوى الهيموغلوبين في الدم، الذي يشير إلى فقر الدم، بل وأيضا مستوى كريات الدم الحمراء".
وأضافت, "ارتفاع الهيموغلوبين وكريات الدم الحمراء، يشير إلى ضرورة استشارة الطبيب المختص بامراض الدم. لأن هذا قد يكون مؤشرا لاحتمال الإصابة بسرطان الدم، الذي يتطلب علاجا ومساعدة طبية معينة".
وتابعت , "وفي بعض الأحيان يشير ارتفاع مستوى الصفائح الدموية وكريات الدم البيضاء إلى هذا المرض أيضا".
واردفت، "يمكن أيضا أن يشير انخفاض مستوى كريات الدم البيضاء، إلى احتمال الإصابة بسرطان الدم".
وأوضحت, "انخفاض عدد كريات الدم البيضاء في الدم لا يشعر به الإنسان، مع أن سببه قد يكون ورما حميدا، وهذا كقاعدة لا يحتاج إلى علاج. لأنه لا يشكل أي خطر على حياة الإنسان".
وفي الختام, نصحت بضرورة إجراء تحاليل الدم الأساسية على الأقل مرة واحدة سنويا
تــابــــع كــل الأخــبـــــار.
إشترك بقناتنا على واتساب

Follow: Lebanon Debate News

الـــمــــزيــــــــــد
الـــمــــزيــــــــــد





